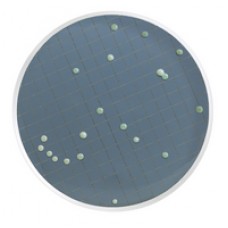
MEIO WALLERSTEIN EM AMPOLA 2ml PARA BACTERIAS MOFOS E LEVEDURAS (CX) MILLIPORE
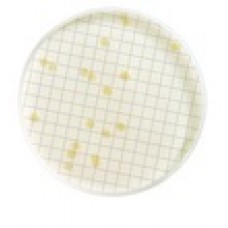
MEIO TGE CALDO DESIDRATADO PÓ FRASCO COM 113,5g PARA CONTAGEM TOTAL DE BACTERIAS (EMB) MILLIPORE

MEMBRANA ULTRACEL PLCC 5KNMWL DIAM 63.5mm CELULOSE REGENERADA (CX) MILLIPORE
Modelo: PLCC06210
R$1.028,70
MEMBRANA ULTRACEL PLCC 5KNMWL DIAM 44.5mm CELULOSE REGENERADA (CX) MILLIPORE
Modelo: PLCC04310
R$1.297,83
MEMBRANA ULTRACEL PLCC 5KMNWL DIAM 47mm CELULOSE REGENERADA (CX) MILLIPORE
Modelo: PLCC04710
R$1.168,73
MEMBRANA ULTRACEL PLBC 3KNMWL DIAM 90mm CELULOSE REGENERADA (CX) MILLIPORE
Modelo: PLBC09005
R$2.028,42
MEMBRANA ULTRACEL PLBC 3KNMWL DIAM 76mm CELULOSE REGENERADA (CX) MILLIPORE
Modelo: PLBC07610
R$1.255,17
MEMBRANA ULTRACEL PLBC 3KNMWL DIAM 74mm CELULOSE REGENERADA (CX) MILLIPORE
Modelo: PLBC04710
R$1.168,73
MEMBRANA ULTRACEL PLBC 3KNMWL DIAM 63,5mm CELULOSE REGENERADA (CX) MILLIPORE
Modelo: PLBC06210
R$1.021,23
MEMBRANA ULTRACEL PLBC 3KNMWL DIAM 44,5mm CELULOSE REGENERADA (CX) MILLIPORE
Modelo: PLBC04310
R$1.182,53
MEMBRANA ULTRACEL PLAC 1KNMWL DIAM 76mm CELULOSE REGENERADA (CX) MILLIPORE
Modelo: PLAC07610
R$1.259,44
MEMBRANA ULTRACEL PLAC 1KNMWL DIAM 63,5mm CELULOSE REGENERADA (CX) MILLIPORE
Modelo: PLAC06210
R$1.039,39
MEMBRANA ULTRACEL PLAC 1KNMWL DIAM 47mm CELULOSE REGENERADA (CX) MILLIPORE
Modelo: PLAC04710
R$1.168,73
MEMBRANA ULTRACEL PLAC 1KNMWL DIAM 43mm CELULOSE REGENERADA (CX) MILLIPORE
Modelo: PLAC04310
R$1.005,20
MEMBRANA ULTRACEL PLAC 1KNMWL DIAM 25mm CELULOSE REGENERADA (CX) MILLIPORE
Modelo: PLAC02510
R$806,87
MEIO WALLERSTEIN EM AMPOLA 2ml PARA BACTERIAS MOFOS E LEVEDURAS (CX) MILLIPORE
Modelo: MHA000P2N
R$1.292,92
MEIO TGE CALDO DESIDRATADO PÓ FRASCO COM 113,5g PARA CONTAGEM TOTAL DE BACTERIAS (EMB) MILLIPORE
Modelo: MB000000T